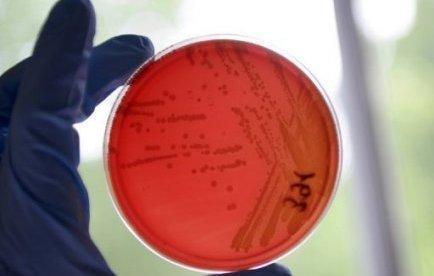

Bean sprouts are responsible; alert on vegetables lifted
Germany
Friday 10 June 2011
MD
The 3 German health establishments lift the ban on the consumption of raw vegetables.
German authorities have announced that bean sprouts are the source of the outbreak that killed 30 people in Europe.
The 3 German federal health institutes have announced that bean sprouts produced at a farm north of Bienenbüttel Germany are the cause of the epidemic.
They have officially announced the lifting of the alert decreed at the end of May against the consumption of cucumbers, tomatoes and raw salads, which has already cost hundreds of millions of euros to European farmers.
source : afp